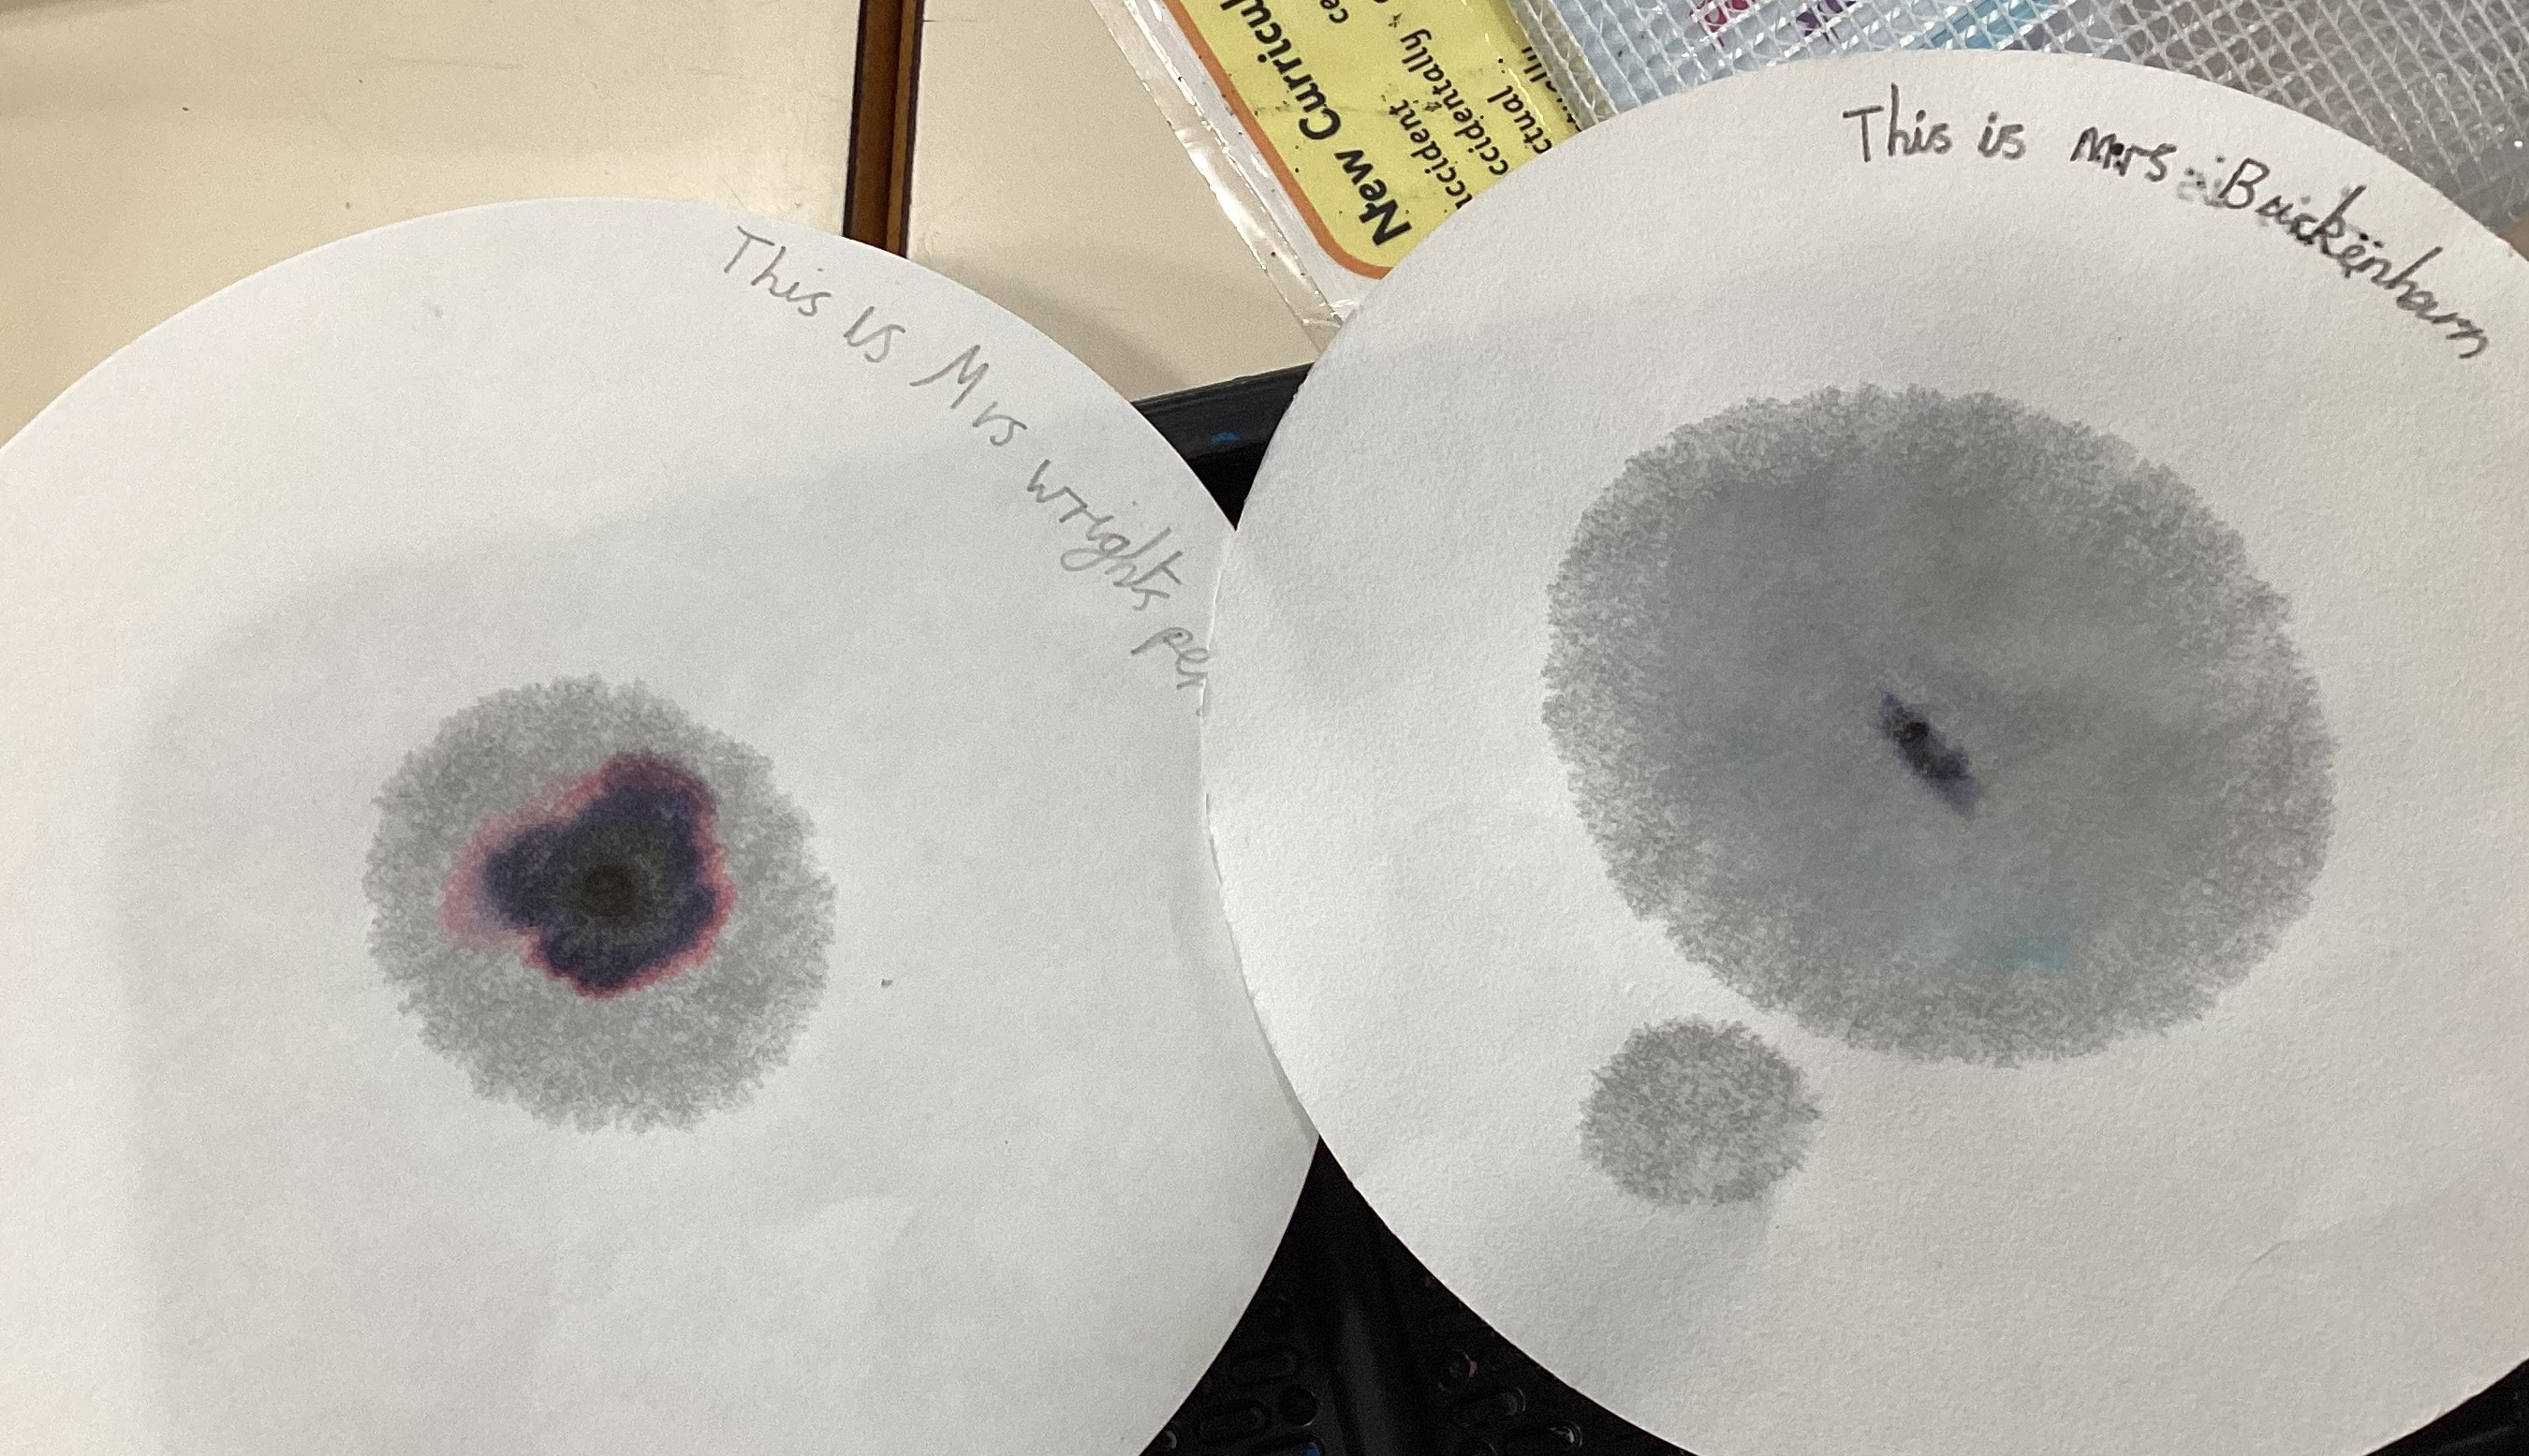

CRIME-SOLVING CHROMATOGRAPHISTS

Did you know you can solve crimes using chromatography?
The children in Amazon Class were surprised to find a ransom note in their class this week in the space where the biscuit box is normally kept. There were very few clues about who had written the note, but, thankfully, the culprit hadn’t factored in the children’s amazing forensic science skills when planning their dastardly crime.
Thinking and acting quickly, the children gathered pens used by different teachers around the school. They then used chromatography to identify a match for the ink used by the thief to write their ransom note.
Chromatography is the science of separating ink into its component dyes. The children used filter paper and pipettes to carefully drop water onto ink dots to find a match for the pen used.
A match found, the culprit was identified and the biscuits returned to the class.
Well done science detectives!